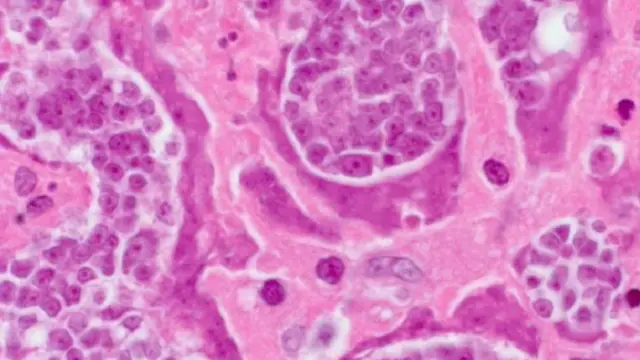

පිළිකා - 90% කට හේතුව මිනිස් ජීවන රටාව හා පරිසරය

ඡායාරූප මූලාශ්රය, Thinkstock
පිළිකා රෝග වලින් සියයට අනූවක්ම ඇතිවීමට පාරිසරික සහ දුම් බීම සහ අධික මත් පැන් භාවිතය ඇතුළු මිනිසාගේ ජීවන රටාව හේතු වන බව ඇමරිකා එක්සත් ජනපදයේ කළ අධ්යයනයකින් හෙළි වෙයි.
මෙම අධ්යයනය සිදු කරන ලද්දේ නිව්යෝර්ක් නුවර මූලස්ථානය කොට ගත් ස්ටෝනි බ්රූක් විශ්ව විද්යාලයේ පර්යේෂකයන් විසින්.
ඔවුන්ගේ අධ්යයනයට , පිළිකා රෝගයට අදාළ දත්ත යළි විශ්ලේෂණයට ලක් කිරීම මගින් සොයා ගත් තොරතුරු පාදක කොට ගෙන තිබේ.
ඡායාරූප මූලාශ්රය, CDC
විෂ රසායනික සහ විකිරණ වැනි බාහිර බලපෑමකින් තොරව රුධිර සෛලවල අහඹු ලෙස සිදු වන ජාන විපර්යාස මගින් පිළිකා වැළඳීම සිදුවන්නේ කලාතුරකින් බව ඔවුන්ගේ සොයා ගැනීම්වලින් හෙළිවී තිබේ.
මෙම පර්යේෂණ ප්රතිඵල පිළිකා රෝග වැළැක්වීමේ මූලෝපායන් යළි නිශ්චය කිරීමට ආධාර වන බව පර්යේෂකයෝ ප්රකාශ කරති.
පිළිකා රෝග වලින් බොහොමයක් හට ගන්නේ සෛලවල අහඹු ලෙස සිදු වන ජාන විපර්යාස මගින් බවට මීට කලින් කරන ලද පර්යේෂණ තොරතුරු නව අධ්යයනය මගින් අභියෝගයට ලක් කොට තිබේ.




